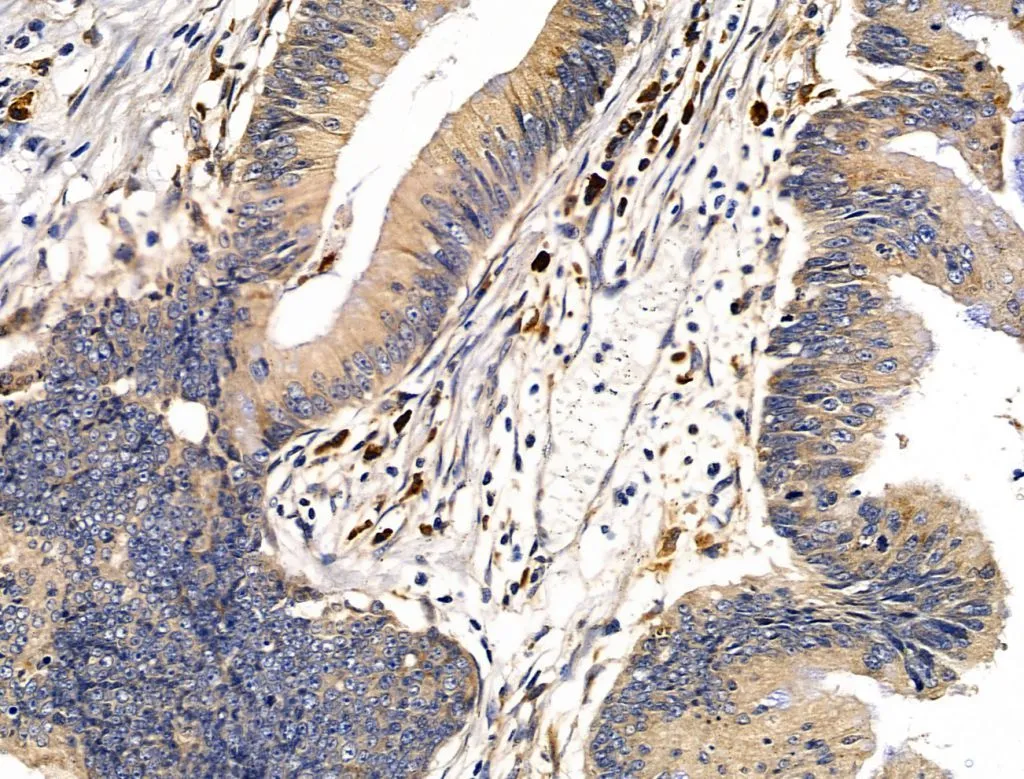

ICC/IF analysis of PFA-fixed HeLa cells using GTX03451 gp340 antibody. Red : Primary antibody Green : beta tubulin Blue : DAPI Permeabilization : 0.1% Triton X-100 Dilution : 1:200
gp340 antibody
GTX03451
ApplicationsImmunoFluorescence, Western Blot, ImmunoCytoChemistry, ImmunoHistoChemistry, ImmunoHistoChemistry Paraffin
Product group Antibodies
TargetDMBT1
Overview
- SupplierGeneTex
- Product Namegp340 antibody
- Delivery Days Customer9
- Application Supplier NoteWB: 1:500-1:2000. ICC/IF: 1:100-1:500. IHC-P: 1:50-1:200. *Optimal dilutions/concentrations should be determined by the researcher.Not tested in other applications.
- ApplicationsImmunoFluorescence, Western Blot, ImmunoCytoChemistry, ImmunoHistoChemistry, ImmunoHistoChemistry Paraffin
- CertificationResearch Use Only
- ClonalityPolyclonal
- Concentration1 mg/ml
- ConjugateUnconjugated
- Gene ID1755
- Target nameDMBT1
- Target descriptiondeleted in malignant brain tumors 1
- Target synonymsGP340, SAG, SALSA, muclin, scavenger receptor cysteine-rich domain-containing protein DMBT1, glycoprotein 340, hensin, salivary agglutinin, salivary scavenger and agglutinin, surfactant pulmonary-associated D-binding protein, vomeroglandin
- HostRabbit
- IsotypeIgG
- Protein IDQ9UGM3
- Protein NameScavenger receptor cysteine-rich domain-containing protein DMBT1
- Scientific DescriptionLoss of sequences from human chromosome 10q has been associated with the progression of human cancers. This gene was originally isolated based on its deletion in a medulloblastoma cell line. This gene is expressed with transcripts of 6.0, 7.5, and 8.0 kb in fetal lung and with one transcript of 8.0 kb in adult lung, although the 7.5 kb transcript has not been characterized. The encoded protein precursor is a glycoprotein containing multiple scavenger receptor cysteine-rich (SRCR) domains separated by SRCR-interspersed domains (SID). Transcript variant 2 (8.0 kb) has been shown to bind surfactant protein D independently of carbohydrate recognition. This indicates that DMBT1 may not be a classical tumor suppressor gene, but rather play a role in the interaction of tumor cells and the immune system. [provided by RefSeq, Mar 2016]
- Storage Instruction-20°C or -80°C,2°C to 8°C
- UNSPSC12352203